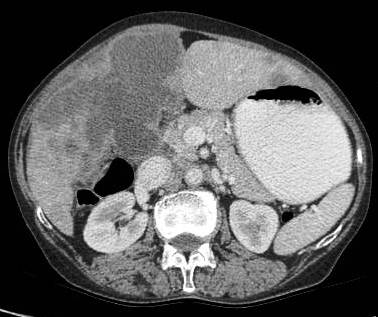
Figure 3: large polypoidal fungating gallbladder mass with gross invasion of liver parenchyma. Hepato-duodenal ligament invaded. Left lobe shows discrete secondaries.
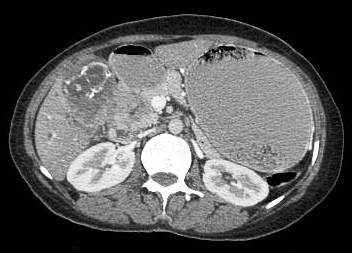
Figure 9: locally aggressive lesion showing infiltrative gallbladder mass invading the antro-pyloric region, first and second part of duodenum. Patient had gastric outlet obstruction. Incarcerated calculi can be seen.
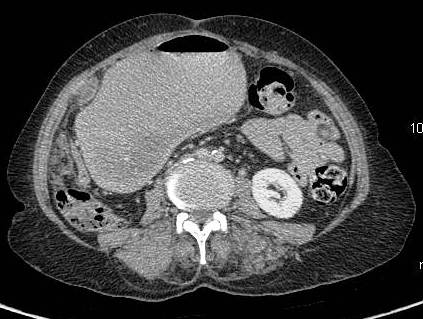
Figure 18: patient with advance carcinoma with discrete nodular peritoneal deposits and gastric outlet obstruction.

Aggressive Nature and Loco-regional Spread of Carcinoma Gallbladder: a 64 Channel Multi-detector Computerized Tomographic Pictorial Review
Amit Nandan Dhar Dwivedi1, Lovekesh Bhatia1, Manoj Pandey2, Vijay Kumar Shukla3, Ram Chandra Shukla1
- 1Department of Radiology and Imaging, Institute of Medical Sciences, Banaras Hindu University, Varanasi, India
- 2Department of Surgical Oncology, Institute of Medical Sciences, Banaras Hindu University, Varanasi, India
- 3Department of General Surgery, Institute of Medical Sciences, Banaras Hindu University, Varanasi, India
- Submitted: June 13, 2012;
- Accepted July 17, 2012
- Published: July 30, 2012
This is an Open Access article distributed under the terms of the Creative Commons Attribution License (http://creativecommons.org/licenses/by/3.0), which permits unrestricted use, distribution, and reproduction in any medium, provided the original work is properly cited.
Introduction:
Carcinoma of the gallbladder is the commonest neoplasm of the hepatobiliary tract in this part of India. The disease is usually diagnosed at late stage and has poor prognosis.
Aim:
The aim of this pictorial review is to illustrate the aggressive spread and biological behavior of carcinoma gall bladder using a 64 slice computerized tomography (CT) scanner.
Patients and Methods:
Retrospective review of cases of carcinoma gallbladder that underwent imaging with 64 slice computerized tomography scan at Institute of Medical Sciences, Varanasi.
Conclusions:
Indians are ethnically and culturally different from their Western counterparts, for whom the incidence of this disease is comparatively low. Incidence of carcinoma gallbladder is higher in this geographical belt. Studies from India suggest that cases from this geographical belt are more aggressive
Introduction
The incidence of gallbladder cancer varies in different parts of the world. Approximately 6,500 new cases of gallbladder carcinoma are reported annually in the United States, with a 4:1 female-to-male ratio and the peak incidence occurring in the sixth and seventh decades of life. .This sex predilection is thought to be related to the higher incidence of cholelithiasis in women, since 70% to 80% of gallbladder carcinomas are associated with gallstones [1-3]. Carcinoma of the gallbladder (GB) is the most common malignancy of the biliary tract and the third most common gastrointestinal malignancy in and around the Varanasi region of India [4] . Within the Indian population it is much higher in Northern cities [5]. The incidence of gallbladder cancer varies in different parts of the world. The knowledge of the patterns of appearance of the primary tumor and familiarity with its typical modes of loco-regional spread from a distinct geographical belt will be helpful to shed light on the biological behavior of this aggressive tumor.
Results
Common patterns of carcinoma gallbladder
Three patterns have been described on ultrasonography (US). The gallbladder fossa is replaced by a heterogeneous mass (figure 1) with internal areas of necrosis; or there may be diffuse, irregular, and asymmetrical wall thickening (Figure 2); or less commonly, a polypoidal, fungating intra-luminal mass is seen. Correct preoperative diagnosis has improved considerably with the use of newer imaging techniques [6-8]. Majority of cases when diagnosed, are no longer resectable (Figure 3) [9-11].

Figure 1: Large gallbladder fossa mass replacing the entire gallbladder. Discrete liver secondaries can be seen.

Figure 2: Diffuse infiltrative carcinoma of the gallbladder with irregular wall thickening and invasion of liver parenchyma. Medially the plane with second part of duodenum is invaded. Inferiorly right perinephric fat plane invaded
Figure 3: Large polypoidal fungating gallbladder mass with gross invasion of liver parenchyma. Hepato-duodenal ligament invaded. Left lobe shows discrete secondaries.
Association with cholelithiasis
Etiology of gallbladder cancer remains obscure although cholelithiasis (Figure 4,5) [3-5], cholecystitis [12], racial and ethnic factors, blood groups, carcinogens, lipid peroxidation products, benign tumors, and secondary bile acids have been implicated as possible causes [13-15].

Figure 4: Gallbladder shows multiple hyperdense incarcerated calculi with loss of normal tissue planes. Gross ascites noted with peritoneal enhancement.

Figure 5: Gallbladder mass associated with large hyperdense calculus. Gross omental deposits and ascites can be seen. Inferiorly on right side the colon is invaded.
Invasion of hepatic parenchyma
The liver bed is frequently invaded and there is local spread to duodenum, stomach and colon (Figure 6). Liver invasion is suggested by lack of distinct margin between the gallbladder mass and the liver (Figure 7). In a study, the stage distribution according to the TNM system revealed 6, 10, 12, and 53 patients at stages I–IV, respectively. The curative resection rate was 22.2%. Stage-dependent surgical procedures resulted in cumulative survival rates of 33.3%for stages I and II, 8.3% for stage III, and 1.9% for stage IV. The overall prognosis was significantly determined by metastatic spread to the lymph nodes [9].

Figure 6: Advance carcinoma showing the entire liver parenchyma studded with secondaries

Figure 7: Infiltrative carcinoma with necrotic lymph node medially and gross invasion of liver parenchyma in the region of fundus.
Invasion of duodenum, hepatic flexure, lesser sac and antro-pyloric region
Majority of tumors are inoperable at the time of diagnosis and average survival is only six months after first symptoms appears. The rich lymphatic and venous drainage of gallbladder allows rapid spread to lymph nodes and widespread dissemination. There is local spread to duodenum, stomach and colon (Figure 8-11).

Figure 8: Advance case showing invasion of hepatic flexure of colon and also involving the antro-pyloric region medially
Figure 9: Locally aggressive lesion showing infiltrative gallbladder mass invading the antro-pyloric region, first and second part of duodenum. Patient had gastric outlet obstruction. Incarcerated calculi can be seen.

Figure 10: Patient with ascites and peritoneal deposits. There is gross invasion of first and second part of duodenum.

Figure 11: Large fundal mass with invasion of colon and medially involving the gasro-hepatic ligament. Discrete peritoneal deposits can be seen.
Invasion of biliary radicals
Biliary obstruction in the form of dilated intra-hepatic biliary radicals and common bile duct (CBD) may be seen because of direct extension via hepato-duodenal ligament (Figure 12,13) or compression by lymphadenopathy (Figure 14).

Figure 12: Gross hepatomegaly with dilatation of right and left hepatic duct. The confluence is disrupted due to gallbladder neck mass.

Figure 13: Image showing gross intra hepatic biliary radical dilatation and direct invasion of right main portal vein.
Vascular invasion and nodal metastasis
Hematogenous distant metastases may also be seen. Enlarged lymph nodes may be seen at the portahepatis, peri-pancreatic and para-aortic region (Figure 14-16). Vascular metastases are much less frequent, but can occur. Invasion of portal vein or tumor thrombus can be seen in aggressive or late cases (Figure 13,14). Studies from India suggest that cases from this geographic belt are more aggressive [16].

Figure 14: Another case showing biliary dilatation and attenuation of right main portal vein. Patient had bulky nodes at porta causing biliary dilatation.

Figure 15: CT scan image showing large bulky necrotic nodes in the peri-pancreatic region.

Figure 16: Unusual case of infiltrative gallbladder lesion with large necrotic peripancreatic and conglomerate retroperitoneal nodes. The case mimicks cacinoma head pancreas, however the pancreatic duct was normal and head pancreas effaced. Biliary dilatation is obvious.
Peritoneal involvement and ascites
Intraperitoneal spread is common with ascites, omental nodules and peritoneal implants. In a study [17] on 69 patients of GBC (Figure 17,18) who underwent exploratory laparotomy, 76.8% had liver involvement, 71% had lymph node involvement, and 24.6% had peritoneal deposits. Preoperative staging using multislice CT has had an overall accuracy ranging from 83 to 86% [18,19].

Figure 17: Patient of infiltrative carcinoma with ascites cholelithiasis and peritoneal enhancement.
Figure 18: Patient with advance carcinoma with discrete nodular peritoneal deposits and gastric outlet obstruction.
Conclusion
This pictorial essay gives insight about the biological behavior of carcinoma gallbladder and its features affecting the neighboring structures and diagnostic dilemma which it can produce. The review gives valuable information about the aggressiveness and biological behavior of carcinoma gallbladder, its epidemiology and role of multi scanner CT in defining this disease and diagnostic pearls.
Authors' Contribution
AND: Designed and conceived the study, edited the manuscript.
LB: Literature search and preparation of draft manuscript.
MP: Preparation of manuscript and intellectual content.
VKS: Preparation of manuscript and intellectual content.
RCS: Intellectual content and edited the manuscript.
Conflict of Interests
The authors declare that there are no conflicts of interests.
Ethical Considerations
This manuscript report on retrospective review of CT scans, ethical permission is not required.
Funding
None
Acknowledgement
None
References
[1]. Kapoor VK, Mc Michael AJ. Gallbladder cancer: An ‘Indian” disease. Natl Med J India. 2003;16: 209-13. [Pubmed]
[2]. Maram ES, Ludwig J, Kurland LT, Brian DD. Carcinoma of the gallbladder and extrahepatic biliary ducts in Rochester, Minnesota, 1935--1971. Am J Epidemiol. 1979; 109: 152–75. [Pubmed]
[3]. Nervi F, Duarte I, Gómez G, Rodríguez G, Del Pino G, Ferrerio O, Covarrubias C, Valdivieso V, Torres MI, Urzúa A. Frequency of the gallbladder cancer in Chile. Int J Cancer. 1988; 41: 657-60. [Pubmed]
[4]. Shukla VK, Khandelwal C, Roy SK, Vaidya MP. Primary carcinoma of gallbladder: A review of a 16- year period at the university hospital. J Surg Oncol. 1985;28:32-35. [Pubmed]
[5]. National Cancer registry Programme: Consolidated report of the population based cancer registries 1990-1996, Incidence and distribution of cancer, New Delhi: Indian Council of Medical Research, ICMR; 2001:52-53.
[6]. Soira M, Aro K, Pamilo M, Palvansalo M, Suramo I, Taavitsainen M. Ultrasonography in carcinoma of gallbladder. Acta Radiol. 1987; 28: 711-4. [Pubmed]
[7]. Palma LD, Rizzatto G, Pozzi-Mercerri RS, Bazzoccbi M. Gray scale ultrasonography in the evaluation of the carcinoma of the gallbladder. Br J Radiol. 1980; 53: 662-7. [Pubmed]
[8]. Itai Y, Araki T, Yoshikawa K, Fureri S, Yashiro N, Tasaka A. Computed tomography of gallbladder carcinoma. Radiology. 1980; 137: 713-8.[Pubmed]
[9]. Rückert JC, Rückert RI, Gellert K, Hecker K, Müller JM. Surgery for carcinoma of the gallbladder. Hepatogastroenterology. 1996; 43: 527-33.[Pubmed]
[10]. Fong Y, Wagman L, Gonen M, Crawford J, Reed W, Swanson R, Pan C, Ritchey J, Stewart A, Choti M. Evidence-based gallbladder cancer staging: Changing cancer staging by analysis of data from the National Cancer Database. Ann Surg. 2006; 243: 767-71. [Pubmed]
[11]. Kiran RP, Pokala N, Dudrick SJ. Incidence pattern and survival for gallbladder cancer over three decades--an analysis of 10301 patients. Ann Surg Oncol. 2007; 14: 827-32. [Pubmed]
[12]. Piehler JM, crichlow RW. Primary carcinoma of gallbladder. A collective review. Surg Gynecol Obstet. 1978; 147:929-42. [Pubmed]
[13]. Pandey M, Gautam A, Shukla VK. ABO and Rh blood groups in patients with cholelithiasis and carcinoma of the gallbladder. Br Med J. 1995; 310: 1639. [Pubmed]
[14]. Shukla VK, Shukla PK, Pandey M, Rao BR, Roy SK. Lipid peroxidation products in bile from patients with carcinoma of the gallbladder. A preliminary study. J Surg Oncol. 1994; 54: 258-62. [Pubmed]
[15]. Pandey M, Shukla VK, Singh S, Roy SK, Rao BR. Biliary lipid peroxidation products in gallbladder cancer: increased peroxidation or biliary stasis?. Eur J Cancer Prev. 2000; 9: 417-22. [Pubmed]
[16]. Kapoor VK, Pradeep R, Haribhakti SP, Sikora SS, Kaushik SP. Early carcinoma of gallbladder: An elusive disease. J Surg Oncol. 1996; 62: 284-7. [Pubmed]
[17]. Pandey M, Pathak AK, Gautam A, Aryya NC, Shukla VK. Carcinoma of the gallbladder: a retrospective review of 99 cases. Dig Dis Sci. 2001; 46: 1145-51. [Pubmed]
[18]. Yoshimitsu K, Honda H, Shinozaki K, Aibe H, Kuroiwa T, Irie H, Chijiiwa K, Asayama Y, Masuda K. Helical CT of the local spread of carcinoma of the gall bladder: Evaluation of the gall bladder: Evaluation according to the TNM system in patients who underwent surgical resection. AJR Am J Roentgenol 2002; 179: 423-8. [Pubmed]
[19]. Grand D, Horton MK, Fishman EK. CT of the gallbladder: Spectrum of disease. AJR Am J Roentgenol 2004; 183: 163-70. [Pubmed]


